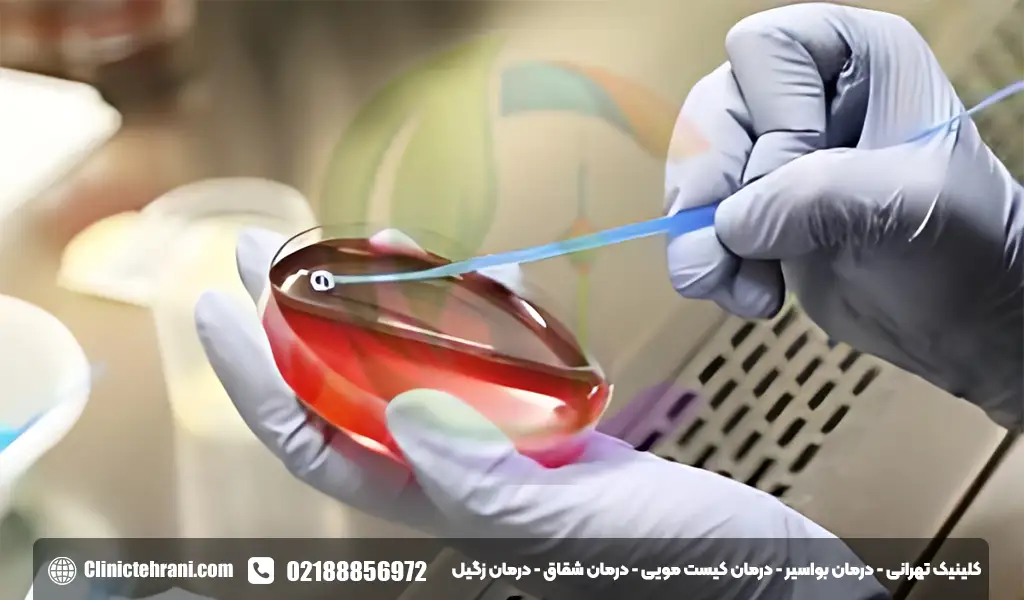
عکس ادرار خونی

مشاهده خون در ادرار یا به اصطلاح پزشکی هماچوری (Hematuria)، تجربهای نگرانکننده است که میتواند هر فردی را با استرس و سوالات متعددی روبرو کند. این پدیده که باعث تغییر رنگ ادرار به صورتی، قرمز یا قهوهای میشود، همیشه به معنای یک بیماری خطرناک نیست، اما هرگز نباید نادیده گرفته شود. ادرار خونی میتواند به دو شکل «هماچوری آشکار» (Gross Hematuria) که با چشم غیرمسلح دیده میشود و «هماچوری میکروسکوپی» (Microscopic Hematuria) که فقط زیر میکروسکوپ قابل تشخیص است، رخ دهد.
در هر دو حالت، این علامت یک زنگ خطر از سوی بدن است که به ما میگوید باید به دنبال علت اصلی آن باشیم. بررسی دقیق و تشخیص صحیح علت، اولین و مهمترین قدم برای درمان و حفظ سلامتی است. گاهی اوقات، برخی علائم ممکن است با یکدیگر اشتباه گرفته شوند. برای مثال، وجود خون در مدفوع که ناشی از بیماریهایی مانند شقاق مقعدی است، یک مسئله کاملا متفاوت از ادرار خونی است و نیاز به بررسیهای تخصصی در حوزه بیماریهای نشیمنگاهی دارد.
در این زمینه، کلینیک تهرانی به عنوان یک مرکز تخصصی و معتبر در تشخیص و درمان بیماریهای ناحیه آنورکتال مانند درمان شقاق مقعدی، بواسیر و سایر اختلالات مرتبط، آماده ارائه خدمات تشخیصی و درمانی پیشرفته به مراجعین محترم است تا با تشخیص افتراقی صحیح، مسیر درمانی مناسب برای هر بیمار مشخص گردد.
فهرست عناوین
- خون در ادرار
- خون در ادرار نشانه چیست
- آیا وجود خون در ادرار خطرناک است؟
- چه مقدار خون در ادرار خطرناک است؟
- علت خون در ادرار
- علت چند قطره خون بعد از ادرار در زنان
- علت خون در ادرار زنان نشانه چیست
- چند قطره خون بعد از ادرار در مردان
- علت خون در ادرار مردان نشانه چیست
- درد پهلو و خون در ادرار نشانه چیست
- عکس ادرار خونی
- درمان خون در ادرار
- درمان خون در ادرار آقایان
- درمان خون در ادرار زنان
خون در ادرار
وجود ادرار خونی که از نظر علمی هماچوری نامیده میشود، به معنای حضور گلبولهای قرمز خون (RBCs) در ادرار است. سیستم ادراری طبیعی، شامل کلیهها، حالبها (لولههای اتصال کلیه به مثانه)، مثانه و مجرای ادرار، به گونهای طراحی شده است که از نشت خون به داخل ادرار جلوگیری میکند. کلیهها خون را تصفیه کرده و مواد زائد را به شکل ادرار دفع میکنند، اما سلولهای خونی را به جریان خون بازمیگردانند. بنابراین، وقتی گلبولهای قرمز در ادرار یافت میشوند، نشاندهنده آن است که در نقطهای از این مسیر، از کلیهها گرفته تا مجرای خروجی ادرار، یک آسیب، التهاب یا بیماری وجود دارد که باعث نشت خون شده است.
پدیده ادرار خونی میتواند علل بسیار متنوعی داشته باشد؛ از یک عفونت ساده و قابل درمان در مجاری ادراری گرفته تا شرایط پیچیدهتر مانند سنگ کلیه، بیماریهای کلیوی یا حتی تومورها. گاهی اوقات، تغییر رنگ ادرار به دلیل مصرف برخی داروها، مواد غذایی خاص (مانند چغندر یا لبو) یا رنگهای خوراکی رخ میدهد که این حالت هماچوری کاذب نامیده میشود و با خون در ادرار واقعی متفاوت است. تشخیص دقیق بین این موارد تنها از طریق آزمایش ادرار و بررسیهای پزشکی امکانپذیر است تا علت اصلی مشخص شده و اقدامات درمانی لازم صورت گیرد.
خون در ادرار نشانه چیست
اینکه ادرار خونی نشانه چیست، سوالی کلیدی است که پاسخ آن به مجموعهای از عوامل بستگی دارد. این علامت بهخودیخود یک بیماری نیست، بلکه هشداری از سوی بدن مبنی بر وجود یک مشکل زمینهای در سیستم ادراری یا حتی سایر ارگانها است. در بسیاری از موارد، بهویژه در افراد جوان، علت آن خوشخیم و موقتی است، مانند یک عفونت ادراری (UTI) که معمولا با علائمی همچون سوزش ادرار، تکرر ادرار و درد در ناحیه زیر شکم همراه است. ورزشهای سنگین و شدید نیز میتوانند به دلیل آسیبهای میکروسکوپی به مثانه یا دهیدراتاسیون، به طور موقت باعث بروز هماچوری شوند که معمولا طی یک یا دو روز برطرف میگردد.
با این حال، پاسخ به سوال خون در ادرار نشانه چیست میتواند به شرایط جدیتری نیز اشاره داشته باشد. سنگهای کلیه یا مثانه با حرکت در مجاری ادراری و ایجاد خراشیدگی، باعث خونریزی میشوند که اغلب با درد شدید و پهلو همراه است. بیماریهای کلیوی مانند گلومرولونفریت (التهاب فیلترهای کلیه)، بیماری کلیه پلیکیستیک یا آسیب مستقیم به کلیه نیز از دلایل مهم هماچوری هستند. در مردان مسن، بزرگ شدن خوشخیم پروستات (BPH) میتواند با فشار بر مجرای ادرار منجر به خونریزی شود. همچنین، نباید از احتمال وجود تومورهای خوشخیم یا بدخیم در کلیه، مثانه یا پروستات غافل شد که این موارد نیازمند بررسی فوری و تخصصی هستند.
در این بخش برای شما کاربران بیان میکنیم ادرار خونی نشانه چیست:
- عفونتهای دستگاه ادراری (UTIs): شایعترین علت، بهخصوص در زنان.
- سنگ کلیه یا مثانه: باعث ایجاد خراشیدگی و خونریزی میشوند.
- بزرگ شدن پروستات (BPH): در مردان بالای ۵۰ سال بسیار رایج است.
- بیماریهای کلیوی: مانند گلومرولونفریت یا عفونت کلیه (پیلونفریت).
- آسیب یا ضربه فیزیکی: ضربه به کلیهها یا ناحیه شکم.
- ورزشهای شدید: به ویژه در دوندگان مسافتهای طولانی.
- سرطان: تومورهای مثانه، کلیه یا پروستات.
- مصرف برخی داروها: مانند داروهای ضدانعقاد (وارفارین)، آسپرین و برخی آنتیبیوتیکها.
- بیماریهای ارثی: مانند بیماری سلول داسیشکل یا سندرم آلپورت.

آیا وجود خون در ادرار خطرناک است؟
اینکه آیا وجود خون در ادرار خطرناک است یا خیر، به طور مستقیم به علت زمینهای آن بستگی دارد و نمیتوان یک پاسخ قطعی برای همه افراد ارائه داد. در بسیاری از موارد، بهخصوص اگر هماچوری پس از یک عفونت ادراری یا فعالیت ورزشی سنگین ظاهر شده و به سرعت برطرف شود، جای نگرانی جدی وجود ندارد. با این حال، اصل کلیدی این است که هرگز نباید ادرار خونی را نادیده گرفت. این علامت همیشه نیازمند ارزیابی پزشکی است تا اطمینان حاصل شود که یک بیماری جدی و پنهان، عامل آن نیست. حتی یک بار مشاهده خون در ادرار، حتی اگر دیگر تکرار نشود، دلیلی کافی برای مراجعه به پزشک است.
خطر اصلی زمانی مطرح میشود که وجود خون در ادرار ناشی از بیماریهای خاموش اما پیشرونده مانند سرطان مثانه یا کلیه باشد. در این شرایط، هماچوری ممکن است تنها علامت اولیه باشد و تشخیص زودهنگام میتواند تفاوت چشمگیری در موفقیت درمان و پیشآگهی بیمار ایجاد کند. به همین دلیل، پزشکان معمولا با مشاهده این علامت، مجموعهای از بررسیها شامل آزمایش ادرار، سونوگرافی، سیتیاسکن یا سیستوسکوپی (مشاهده داخل مثانه با دوربین) را برای یافتن علت دقیق توصیه میکنند. بنابراین، خودِ علامت لزوما خطرناک نیست، اما علتی که میتواند پشت آن باشد، پتانسیل خطرناک بودن را دارد و به همین دلیل بررسی آن حیاتی است.
سایت بزرگ و معبر niddk در مقاله ای به پرسش آیا وجود خون در ادرار خطرناک است چنین پاسخ داده است :
Hematuria is a common diagnosis in individuals who visit a urologist. Researchers estimate that at least 1 out of 5 people evaluated by a urologist is diagnosed with hematuria.1 Gross hematuria is less common than microscopic hematuria.2
هماچوری یک تشخیص شایع در افرادی است که به متخصص اورولوژی مراجعه می کنند. محققان تخمین می زنند که حداقل 1 نفر از هر 5 نفری که توسط اورولوژیست ارزیابی می شوند، مبتلا به هماچوری تشخیص داده می شوند. 1 هماچوری ناخالص کمتر از هماچوری میکروسکوپی است.
چه مقدار خون در ادرار خطرناک است؟
این سوال که چه مقدار خون در ادرار خطرناک است، یک تصور اشتباه رایج را هدف قرار میدهد. در واقع، شدت یا مقدار خونریزی لزوما با میزان خطرناک بودن علت آن ارتباط مستقیمی ندارد. ممکن است یک عفونت ادراری ساده باعث خونریزی شدید و تغییر رنگ واضح ادرار به قرمز تیره شود، در حالی که یک تومور سرطانی در مراحل اولیه تنها چند گلبول قرمز میکروسکوپی آزاد کند که با چشم دیده نمیشوند. بنابراین، تمرکز بر روی «مقدار» خون نیست، بلکه «حضور» خون در ادرار است که اهمیت دارد. هرگونه هماچوری، از چند قطره گرفته تا ادرار کاملا قرمز، به عنوان یک علامت هشدار جدی تلقی میشود و نیازمند بررسی پزشکی است.
خطر واقعی به علت زمینهای بستگی دارد، نه به حجم خون. برای مثال، سنگ کلیه میتواند باعث خونریزی شدید و درد طاقتفرسا شود اما معمولا یک وضعیت تهدیدکننده حیات نیست. در مقابل، خون در ادرار که بدون درد و به صورت متناوب ظاهر میشود، میتواند یکی از نشانههای کلاسیک سرطان مثانه باشد، حتی اگر مقدار آن بسیار کم باشد. به همین دلیل، پزشکان هرگز خطرناک بودن شرایط را بر اساس رنگ ادرار یا میزان خون تخمین نمیزنند. اصل اساسی این است: هر مقدار خون، چه کم و چه زیاد، چه یکباره و چه مکرر، باید به طور کامل بررسی شود تا علل جدی و خطرناک رد شوند.
علت خون در ادرار
علت خون در ادرار میتواند از دهها عامل مختلف، از مشکلات خوشخیم و گذرا گرفته تا بیماریهای جدی و نیازمند درمان فوری، نشات بگیرد. سیستم ادراری انسان (شامل کلیهها، حالبها، مثانه و مجرای ادرار) یک مسیر بسته است و هرگونه آسیب، التهاب یا ناهنجاری در این مسیر میتواند به دیواره رگهای خونی آسیب رسانده و باعث نشت گلبولهای قرمز به داخل ادرار شود. این پدیده که هماچوری نام دارد، یک علامت است، نه یک بیماری؛ بنابراین، کلید درمان در یافتن و مدیریت علت اصلی نهفته است.
شناسایی دقیق علت ادرار خونی نیازمند یک رویکرد تشخیصی نظاممند است که معمولا با تاریخچه پزشکی بیمار، معاینه فیزیکی و آزمایش ادرار آغاز میشود. در مراحل بعدی، ممکن است از ابزارهای تصویربرداری مانند سونوگرافی، سیتیاسکن یا MRI و در برخی موارد از سیستوسکوپی (آندوسکوپی مثانه) برای مشاهده مستقیم ساختارهای داخلی استفاده شود. هر یک از این روشها به پزشک کمک میکند تا منشا خونریزی را پیدا کرده و برنامه درمانی مناسب را تدوین کند.
مهمترین دلایل ادرار خونی عبارتند از:
- عفونتهای دستگاه ادراری (UTI): شامل عفونت مثانه (سیستیت) یا عفونت کلیه (پیلونفریت).
- سنگهای کلیه یا مثانه: لبههای تیز سنگها باعث خراشیدگی و خونریزی میشود.
- بزرگ شدن خوشخیم پروستات (BPH): در مردان مسن، با فشار بر مجرای ادرار باعث خونریزی میشود.
- بیماریهای گلومرولی: التهاب واحدهای تصفیهکننده کلیه (گلومرولها).
- سرطان: تومورهای بدخیم در کلیه، مثانه، پروستات یا حالب.
- آسیب فیزیکی یا تروما: ضربه شدید به پهلوها یا شکم که به کلیهها آسیب میرساند.
- ورزشهای سنگین: به ویژه دویدنهای طولانیمدت که میتواند باعث هماچوری موقت شود.
- داروها: داروهای رقیقکننده خون (مانند وارفارین و آسپرین)، برخی آنتیبیوتیکها (مانند ریفامپین) و داروهای شیمیدرمانی.
- بیماریهای ارثی: مانند بیماری کلیه پلیکیستیک، سندرم آلپورت یا بیماری سلول داسیشکل.
- آندومتریوز: در زنان، زمانی که بافت رحم به مثانه تهاجم میکند.
- التهاب پروستات (پروستاتیت): عفونت یا التهاب غده پروستات.

علت چند قطره خون بعد از ادرار در زنان
مشاهده چند قطره خون بعد از ادرار در خانم ها یک علامت مشخص است که میتواند به دلایل مختلفی رخ دهد و نیازمند توجه ویژه است. این نوع خونریزی که به آن “هماچوری انتهایی” (Terminal Hematuria) نیز گفته میشود، اغلب نشاندهنده وجود یک مشکل در ناحیه مثلث مثانه (Trigone) یا مجرای خروجی ادرار (Urethra) است. یکی از شایعترین دلایل، عفونت مثانه یا سیستیت است. در این حالت، انقباض مثانه در پایان فرآیند ادرار کردن باعث تحریک بیشتر دیواره ملتهب و خونریزی میشود.
با این حال، علت چند قطره خون بعد از ادرار در زنان میتواند به مسائل دیگری نیز مرتبط باشد. پولیپها یا تومورهای کوچک در دهانه مثانه یا مجرای ادرار، سنگهای کوچکی که در حال دفع شدن هستند، یا التهاب مجرای ادرار (اورتریت) که ممکن است ناشی از عفونت یا آسیب باشد، همگی میتوانند چنین علامتی ایجاد کنند. در برخی موارد، ضعف عضلات کف لگن یا شرایطی مانند افتادگی مثانه (سیستوسل) نیز میتواند با تخلیه ناقص و التهاب ثانویه، منجر به این نوع خونریزی شود.
دلایل احتمالی مشاهده قطرات خون پس از ادرار:
- عفونت مثانه (سیستیت): انقباض نهایی مثانه باعث خونریزی از بافت ملتهب میشود.
- التهاب مجرای ادرار (اورتریت): ناشی از عفونت یا تحریک شیمیایی.
- پولیپ یا تومور مثانه یا مجرای ادرار: به خصوص اگر در نزدیکی خروجی مثانه قرار داشته باشند.
- سنگ مثانه یا سنگ در حالب تحتانی: تحریک مکانیکی در انتهای ادرار.
- آتروفی واژن و مجرای ادرار پس از یائسگی: نازک و شکننده شدن بافتها به دلیل کاهش استروژن.
علت خون در ادرار زنان نشانه چیست
وقتی سوال علت خون در ادرار زنان نشانه چیست مطرح میشود، باید به مجموعهای از دلایل مشترک با مردان و همچنین چندین عامل مختص زنان توجه کرد. شایعترین علت هماچوری در زنان، عفونتهای دستگاه ادراری (UTI) است. به دلیل کوتاهتر بودن مجرای ادرار در زنان، باکتریها راحتتر میتوانند به مثانه راه پیدا کرده و باعث التهاب و خونریزی شوند. این وضعیت معمولا با علائمی مانند سوزش، تکرر ادرار و احساس فوریت همراه است.
با این حال، خون در ادرار زنان همیشه به سادگی یک عفونت نیست. گاهی اوقات، تشخیص افتراقی بین خونریزی واژن (مانند خونریزی قاعدگی) و هماچوری واقعی دشوار است و نیاز به نمونهگیری تمیز ادرار دارد. علاوهبر علل عمومی مانند سنگ کلیه و بیماریهای کلیوی، شرایطی مانند آندومتریوز ادراری (رشد بافت رحم در دیواره مثانه) یا فیبرومهای رحمی بزرگ که به مثانه فشار میآورند، میتوانند از دلایل اختصاصی هماچوری در زنان باشند. همچنین، سرطانهای دستگاه ادراری و تناسلی نیز باید به عنوان یک احتمال جدی در نظر گرفته شوند، به خصوص اگر خونریزی بدون درد و مکرر باشد.
برخی از مهمترین دلایل هماچوری در زنان:
- عفونت دستگاه ادراری (UTI): شایعترین علت.
- دوران قاعدگی: احتمال ترکیب شدن خون قاعدگی با ادرار.
- سنگ کلیه یا مثانه.
- آندومتریوز: درگیری مثانه یا حالبها توسط بافت اندومتر.
- سیستیت بینابینی (سندرم مثانه دردناک): یک بیماری التهابی مزمن مثانه.
- بارداری: فشار رحم بر مثانه و افزایش احتمال عفونت ادراری.
- سرطان: سرطان مثانه، کلیه یا دهانه رحم.
- بیماریهای مقاربتی (STIs): مانند کلامیدیا یا سوزاک.

چند قطره خون بعد از ادرار در مردان
مشاهده چند قطره خون بعد از ادرار در مردان، که به آن “خونریزی انتهایی” نیز گفته میشود، علامتی است که به طور خاص به مشکلات موجود در قسمتهای پایانی دستگاه تناسلی مردان، یعنی گردن مثانه، غده پروستات و مجرای ادرار (یورترا) اشاره دارد. هنگامی که مثانه برای تخلیه کامل ادرار منقبض میشود، هرگونه التهاب، انسداد یا ضایعه در این نواحی میتواند تحت فشار قرار گرفته و باعث خونریزی شود. این پدیده نباید با خونریزی اولیه (در ابتدای ادرار) یا خونریزی کامل (در تمام طول ادرار) اشتباه گرفته شود، زیرا محل مشکل را با دقت بیشتری مشخص میکند.
علت چند قطره خون بعد از ادرار در آقایان اغلب به غده پروستات مربوط میشود. پروستاتیت (التهاب پروستات) یا بزرگ شدن خوشخیم پروستات (BPH) میتوانند باعث تحریک و خونریزی در هنگام انقباض نهایی مثانه شوند. همچنین، وجود تنگی در مجرای ادرار یا یک پولیپ یا تومور کوچک در ناحیه گردن مثانه نیز از دلایل احتمالی دیگر است. از آنجایی که این علامت میتواند نشانه اولیه شرایط جدیتری باشد، بررسی دقیق آن توسط اورولوژیست برای تشخیص صحیح و شروع درمان مناسب، امری ضروری است.
این علامت میتواند نشانگر موارد زیر باشد:
- پروستاتیت (التهاب غده پروستات): یکی از شایعترین علل، به ویژه در مردان جوان و میانسال.
- بزرگ شدن خوشخیم پروستات (BPH): فشار ناشی از پروستات بزرگ شده بر روی مجرای ادرار.
- تنگی مجرای ادرار (Urethral Stricture): باریک شدن مجرا که باعث آسیب و خونریزی در انتهای ادرار میشود.
- سنگ مثانه یا سنگ گیر کرده در پروستات: تحریک مکانیکی دیواره مثانه یا پروستات.
- سرطان پروستات یا مثانه: به خصوص تومورهایی که در نزدیکی خروجی مثانه قرار دارند.
- عفونت مجرای ادرار (اورتریت): التهاب لوله خروجی ادرار.
علت خون در ادرار مردان نشانه چیست
وقتی به دنبال پاسخ سوال علت خون در ادرار مردان نشانه چیست هستیم، باید به آناتومی منحصر به فرد مردان و بیماریهای مرتبط با آن توجه ویژهای داشته باشیم. اگرچه بسیاری از علل مانند عفونتهای ادراری و سنگ کلیه با زنان مشترک است، اما مسائل مربوط به غده پروستات نقش بسیار مهمی در هماچوری مردان، به ویژه در سنین بالا، ایفا میکند. بزرگ شدن خوشخیم پروستات (BPH) یکی از شایعترین دلایل است. پروستات بزرگ شده به مجرای ادرار فشار آورده و میتواند باعث پارگی رگهای کوچک و خونریزی شود.
علاوه بر BPH، التهاب پروستات یا پروستاتیت (چه عفونی و چه غیرعفونی) نیز میتواند باعث بروز خون در ادرار مردان همراه با علائمی مانند درد، سوزش و مشکل در ادرار کردن شود. مهمتر از همه، سرطان پروستات، که یکی از شایعترین سرطانها در مردان است، میتواند در مراحل پیشرفتهتر خود را با هماچوری نشان دهد. همچنین، سرطان مثانه و کلیه در مردان (به خصوص افراد سیگاری) شیوع بیشتری نسبت به زنان دارد و هماچوری بدون درد یکی از علائم کلیدی هشداردهنده برای این بیماریهاست.
برخی از مهمترین علت ادرار خونی در مردان:
- بزرگ شدن خوشخیم پروستات (BPH): شایعترین علت در مردان بالای ۵۰ سال.
- التهاب پروستات (پروستاتیت): میتواند در هر سنی رخ دهد.
- سرطان پروستات: به خصوص در مراحل پیشرفتهتر.
- سرطان مثانه یا کلیه: شیوع بالاتر در مردان.
- عفونت دستگاه ادراری (UTI): اگرچه در مردان کمتر شایع است، اما میتواند رخ دهد.
- سنگ کلیه یا مثانه.
- آسیب به مجرای ادرار: ممکن است به دلیل سوندگذاری یا تروما ایجاد شود.
- بیماریهای مقاربتی (STIs).

درد پهلو و خون در ادرار نشانه چیست
ترکیب دو علامت درد پهلو و خون در ادرار یکی از کلاسیکترین و قویترین نشانهها در پزشکی است که تقریبا همیشه به مشکلات کلیوی اشاره دارد. کلیهها در دو طرف ستون فقرات، زیر دندههای انتهایی قرار گرفتهاند و دردی که از این ناحیه منشا میگیرد، به عنوان درد پهلو (Flank Pain) شناخته میشود. وقتی این درد تیز، شدید و موجی (کولیکی) باشد و همزمان ادرار نیز خونی شود، اولین و محتملترین تشخیص، سنگ کلیه است. حرکت سنگ در حالب (لوله باریک بین کلیه و مثانه) باعث ایجاد خراشیدگی، خونریزی و درد شدید و طاقتفرسا میشود.
با این حال، پاسخ به سوال درد پهلو و خون در ادرار نشانه چیست، همیشه به سنگ کلیه محدود نمیشود. عفونت حاد کلیه یا پیلونفریت نیز میتواند باعث بروز این دو علامت به طور همزمان شود، که در این حالت معمولا تب و لرز نیز وجود دارد. انسداد حالب به دلایلی غیر از سنگ، مانند یک لخته خون یا یک تومور، نیز میتواند چنین تصویری را ایجاد کند. همچنین، ضربه یا آسیب فیزیکی مستقیم به ناحیه پهلو که منجر به کوفتگی یا پارگی کلیه شده باشد، از دیگر دلایل مهم این ترکیب علائم است.
این ترکیب علائم میتواند نشاندهنده موارد زیر باشد:
- سنگ کلیه: شایعترین علت، با درد شدید و کولیکی.
- عفونت کلیه (پیلونفریت): معمولا همراه با تب، لرز و حالت تهوع.
- انسداد دستگاه ادراری (Obstructive Uropathy): به دلیل لخته خون، تومور یا تنگی مادرزادی.
- تروما یا آسیب به کلیه: ناشی از تصادف، سقوط یا ضربه ورزشی.
- سرطان کلیه: تومورهای بزرگ میتوانند باعث درد و خونریزی شوند.
- بیماری کلیه پلیکیستیک (PKD): کیستهای بزرگ میتوانند باعث درد و پارگی عروق شوند.
- انفارکتوس کلیه (Renal Infarction): مرگ بافت کلیه به دلیل قطع جریان خون (مثلا توسط یک لخته).
عکس ادرار خونی
دیدن یک عکس ادرار خونی میتواند به افراد کمک کند تا وضعیت خود را بهتر درک کرده و اهمیت مراجعه به پزشک را دریابند. رنگ ادرار در حالت هماچوری میتواند از صورتی کمرنگ (شبیه آب هندوانه)، قرمز روشن، تا قهوهای تیره (شبیه نوشابه) متغیر باشد. این تنوع رنگ به میزان خون، مدت زمان باقی ماندن آن در مثانه و میزان اسیدی بودن ادرار بستگی دارد.
مشاهده یک تصویر واقعی از طیف رنگهای ممکن، به بیمار کمک میکند تا بداند آنچه تجربه میکند یک علامت پزشکی شناختهشده است و میتواند به توصیف دقیقتر وضعیت خود به پزشک کمک کند. گاهی افراد به دلیل عدم اطمینان از آنچه میبینند، مراجعه به پزشک را به تعویق میاندازند؛ این عکس مرجع میتواند این شک را برطرف کرده و آنها را به اقدام سریعتر تشویق کند.
درمان خون در ادرار
درمان خون در ادرار به هیچ وجه بر خودِ علامت متمرکز نیست، بلکه به طور کامل به تشخیص و مدیریت علت زمینهای آن بستگی دارد. از آنجایی که هماچوری یک علامت است و نه یک بیماری، اولین و حیاتیترین قدم، تشخیص دقیق علت توسط پزشک است. هرگونه تلاش برای خوددرمانی بدون دانستن علت، میتواند خطرناک باشد و باعث تاخیر در درمان بیماریهای جدی مانند سرطان شود. پس از تشخیص قطعی، پزشک یک برنامه درمانی مشخص را تدوین میکند که ممکن است از یک دوره آنتیبیوتیک ساده تا جراحیهای پیچیده متغیر باشد.
درمان ادرار خونی کاملا به عامل ایجادکننده وابسته است. به عنوان مثال، اگر علت یک عفونت ساده باشد، با آنتیبیوتیک درمان میشود. اگر سنگ کلیه عامل آن باشد، درمان شامل مدیریت درد، افزایش مصرف مایعات برای دفع سنگ یا استفاده از روشهای سنگشکنی خواهد بود. در مواردی که بیماریهای جدیتری مانند سرطان تشخیص داده شود، گزینههای درمانی شامل جراحی، شیمیدرمانی یا رادیوتراپی خواهد بود. بنابراین، هیچ “درمان واحدی” برای هماچوری وجود ندارد و بهترین راه، پیروی از دستورات پزشک متخصص است.
روشهای درمانی بر اساس علت زمینهای:
- درمان پزشکی (رویکرد اصلی و استاندارد):
- آنتیبیوتیکها: برای درمان عفونتهای دستگاه ادراری (UTI) یا پروستاتیت باکتریایی.
- داروهای کنترلکننده BPH: برای کوچک کردن پروستات یا شل کردن عضلات مثانه در موارد بزرگ شدن خوشخیم پروستات.
- سنگشکنی بروناندامی (ESWL): استفاده از امواج صوتی برای خرد کردن سنگهای کلیه.
- جراحی (اورتروسکوپی، نفرولیتوتومی): برای برداشتن سنگهای بزرگ یا سنگهایی که دفع نمیشوند.
- جراحی برداشتن تومور (TURBT برای مثانه، نفرکتومی برای کلیه): در موارد سرطان.
- داروهای سرکوبکننده سیستم ایمنی: برای درمان بیماریهای گلومرولی خاص.
- درمانهای حمایتی و خانگی (فقط به عنوان مکمل و با مشورت پزشک):
- نوشیدن مایعات فراوان: به رقیق شدن ادرار و دفع عفونتها و سنگهای کوچک کمک میکند. این مهمترین توصیه در بسیاری از موارد است.
- استراحت: به خصوص اگر هماچوری ناشی از ورزش شدید یا آسیب جزئی باشد.
- اجتناب از محرکها: پرهیز از کافئین، الکل، غذاهای تند و نوشیدنیهای گازدار که میتوانند مثانه را تحریک کنند.
- درمان در طب سنتی (باید با احتیاط و حتما پس از تشخیص پزشکی استفاده شود):
- گیاهان ادرارآور (مدر): گیاهانی مانند دماسب، گزنه یا قاصدک ممکن است برای کمک به شستشوی دستگاه ادراری توصیه شوند.
- گیاهان ضدالتهاب: مصرف گیاهانی با خواص ضدالتهابی مانند زردچوبه.
- توجه: استفاده از این روشها هرگز نباید جایگزین درمان پزشکی شود، زیرا ممکن است علائم یک بیماری جدی را پنهان کرده و درمان را به تاخیر بیندازد.
درمان خون در ادرار آقایان
درمان خون در ادرار آقایان به طور خاص نیازمند تمرکز بر بیماریهای شایع در مردان، به ویژه مشکلات پروستات است. پس از رد کردن علل عمومی مانند سنگ کلیه یا عفونت، اورولوژیست معمولا وضعیت غده پروستات را به دقت بررسی میکند. اگر علت، بزرگ شدن خوشخیم پروستات (BPH) باشد، درمان اولیه ممکن است شامل داروهایی مانند آلفابلاکرها (برای شل کردن عضلات مثانه) یا مهارکنندههای 5-آلفا ردوکتاز (برای کوچک کردن پروستات) باشد. در موارد شدیدتر یا عدم پاسخ به دارو، روشهای جراحی کمتهاجمی مانند TURP (برداشتن پروستات از طریق مجرا) ممکن است ضروری باشد.
در صورتی که تشخیص، پروستاتیت (التهاب پروستات) باشد، برنامه درمان ادرار خونی آقایان بسته به نوع آن متفاوت خواهد بود. پروستاتیت باکتریایی نیازمند یک دوره طولانی آنتیبیوتیک است، در حالی که برای نوع غیرباکتریایی، از داروها، فیزیوتراپی کف لگن و تغییر سبک زندگی استفاده میشود. مهمترین و جدیترین علت، سرطان پروستات است که گزینههای درمانی آن از نظارت فعال برای تومورهای کمخطر، تا جراحی رادیکال، رادیوتراپی و هورموندرمانی برای موارد پیشرفتهتر متغیر است. تشخیص زودهنگام در موفقیت درمان نقش کلیدی دارد.
خلاصه رویکردهای درمانی برای ادرار خونی در مردان:
- درمان BPH:
- داروهای آلفابلاکر (مانند تامسولوسین).
- مهارکنندههای 5-آلفا ردوکتاز (مانند فیناستراید).
- جراحی (TURP, HoLEP).
- درمان پروستاتیت:
- آنتیبیوتیکها (برای نوع باکتریایی).
- داروهای ضدالتهاب.
- فیزیوتراپی و مدیریت استرس.
- درمان سرطان پروستات/مثانه:
- جراحی (پروستاتکتومی رادیکال، سیستکتومی).
- پرتودرمانی (رادیوتراپی).
- هورموندرمانی (برای سرطان پروستات).
- شیمیدرمانی یا ایمونوتراپی (برای سرطان مثانه).
- درمان سنگ کلیه یا عفونت:
- مشابه رویکردهای عمومی (آنتیبیوتیک، سنگشکنی، افزایش مایعات).

درمان خون در ادرار زنان
درمان خون در ادرار زنان نیازمند یک رویکرد تشخیصی دقیق است تا علت اصلی به درستی شناسایی شود، زیرا دلایل آن میتواند از یک عفونت ساده تا شرایط پیچیده زنان و زایمان متغیر باشد. شایعترین علت، یعنی عفونت دستگاه ادراری (UTI)، معمولا به سادگی با یک دوره کوتاه آنتیبیوتیک خوراکی درمان میشود. پزشک همچنین توصیه به نوشیدن مایعات فراوان برای کمک به شستشوی سیستم ادراری خواهد کرد. اگر هماچوری به سنگ کلیه مربوط باشد، درمان بر اساس اندازه و محل سنگ تعیین میشود و میتواند شامل مدیریت درد و مصرف مایعات تا روشهای سنگشکنی یا جراحی باشد.
فراتر از علل عمومی، درمان ادرار خونی زنان باید شرایط خاص زنان را نیز در نظر بگیرد. به عنوان مثال، اگر آندومتریوز ادراری تشخیص داده شود، درمان ممکن است شامل هورموندرمانی برای کنترل رشد بافت یا جراحی برای برداشتن ضایعات از روی مثانه باشد. برای سیستیت بینابینی (سندرم مثانه دردناک)، رویکرد درمانی چندوجهی است و شامل تغییرات رژیم غذایی، داروها و فیزیوتراپی کف لگن میشود. در موارد مشکوک به سرطان، اقدامات تشخیصی فوری مانند سیستوسکوپی و تصویربرداری انجام شده و درمان بر اساس نوع و مرحله سرطان (جراحی، شیمیدرمانی، رادیوتراپی) خواهد بود.
خلاصه رویکردهای درمانی در زنان:
- درمان عفونت ادراری (UTI):
- تجویز آنتیبیوتیکهای مناسب.
- افزایش مصرف مایعات.
- درمان سنگ کلیه:
- مدیریت درد و هیدراتاسیون.
- سنگشکنی (ESWL) یا اورتروسکوپی.
- درمان مسائل خاص زنان:
- آندومتریوز: هورموندرمانی یا جراحی لاپاراسکوپی.
- سیستیت بینابینی: دارودرمانی، فیزیوتراپی، و تغییر رژیم غذایی.
- آتروفی واژن (پس از یائسگی): کرمهای استروژن موضعی.
- درمان سرطان (کلیه، مثانه، رحم):
- جراحی برای برداشتن تومور.
- شیمیدرمانی، ایمونوتراپی یا رادیوتراپی بر اساس نیاز.
- مدیریت عمومی:
- بررسی و تنظیم داروهایی که ممکن است باعث خونریزی شوند.
نتیجه گیری
مشاهده خون در ادرار یا ادرار خونی، صرفنظر از مقدار یا تکرار آن، یک علامت هشدار مهم است که هرگز نباید نادیده گرفته شود. این پدیده میتواند ناشی از دلایل بسیار متنوعی، از عفونتهای ساده و قابل درمان گرفته تا بیماریهای جدی مانند سنگ کلیه و سرطان باشد. کلید اصلی، تشخیص دقیق و بهموقع علت زمینهای است. هرگونه تاخیر در مراجعه به پزشک میتواند فرایند درمان را پیچیدهتر کرده و در موارد حاد، بر نتیجه نهایی تاثیر منفی بگذارد. بنابراین، اولین و مهمترین اقدام پس از مشاهده ادرار خونی، مراجعه به پزشک متخصص اورولوژی برای ارزیابی کامل و انجام آزمایشهای لازم است.
در مسیر حفظ سلامتی، تشخیص افتراقی صحیح اهمیت بالایی دارد. گاهی علائم بیماریهای مختلف ممکن است با یکدیگر همپوشانی داشته باشند. به عنوان مثال، تمایز بین مشکلات دستگاه ادراری و بیماریهای ناحیه نشیمنگاهی ضروری است. در این راستا، کلینیک تهرانی به عنوان یک مرکز پیشرو و تخصصی در زمینه تشخیص و درمان بیماریهای آنورکتال مانند درمان شقاق واژن و بواسیر، با بهرهگیری از کادری مجرب و تجهیزات مدرن، به بیماران کمک میکند تا با تشخیص دقیق، بهترین مسیر درمانی را انتخاب کنند و از نگرانیهای ناشی از تشخیص نادرست رهایی یابند.
سوالات متداول (FAQ)
ادرار خونی نشانه چیست؟
ادرار خونی (هماچوری) نشانه وجود یک مشکل در دستگاه ادراری (کلیهها، حالبها، مثانه، مجرا) است. علل آن میتواند از عفونت ادراری، سنگ کلیه، و بزرگ شدن پروستات گرفته تا بیماریهای جدیتری مانند سرطان کلیه یا مثانه متغیر باشد.
علت خون در ادرار زنان نشانه چیست؟
شایعترین علت در زنان عفونت دستگاه ادراری (UTI) است. دلایل دیگر شامل سنگ کلیه، دوران قاعدگی، آندومتریوز، سیستیت بینابینی (سندرم مثانه دردناک) و در موارد نادر، سرطانهای دستگاه ادراری یا تناسلی است.
آیا وجود خون در ادرار خطرناک است؟
لزوما نه، اما همیشه باید جدی گرفته شود. خطرناک بودن آن به علت زمینهای بستگی دارد. از آنجایی که میتواند نشانه بیماریهای خاموش و خطرناکی مانند سرطان باشد، هرگز نباید آن را نادیده گرفت و مراجعه به پزشک برای بررسی علت، ضروری است.
چه مقدار خون در ادرار خطرناک است؟
هیچ سطح ایمنی وجود ندارد. خطرناک بودن هماچوری به “مقدار” خون بستگی ندارد، بلکه به “علت” آن مرتبط است. حتی مقدار میکروسکوپی خون که با چشم دیده نمیشود، میتواند ناشی از یک بیماری جدی باشد. بنابراین هر میزانی از خون در ادرار نیازمند بررسی پزشکی است.


یک ماهی میشه ادرار خونی دارم
تازگیا دچار سوزش هم شده
بنده تکرر ادار خونی دارم
درمان چیست؟
مراجعه به پزشک متخصص
ممنون از نویسنده
مقاله خوب و کاملی بود
مادر من قند دارد و تازگیا خون در ادار ایشون مشاهده شده چیکار کنم؟
بهترین کار مراجعه به پزشک اورولوژیست است
خون در ادرار پسر 18 ساله مشکوک است؟
سلام و درود بهتر است آزمایش های لازمه رو بدهید.
پسرم ۱۰سالشه ۱هفته پیش باپهلو خورد زمین دوروز درد پهلو داشت بعد گفت ادرارش رنگش قهوه ای شدا بعد دوروز هم رنگ ادرار درست شد هم درد پهلو الان میگه وقتی ادرار رو خیلی نگه میدارم بعد چند ساعت که میرم تخلیه بعد از پایان ادرار سر آلتم خونی میشه
سلام درود خون در ادرار وقتی بعد از مدتی قطع نشود می بایستی که شما آزمایش های مربوطه رو بدهید